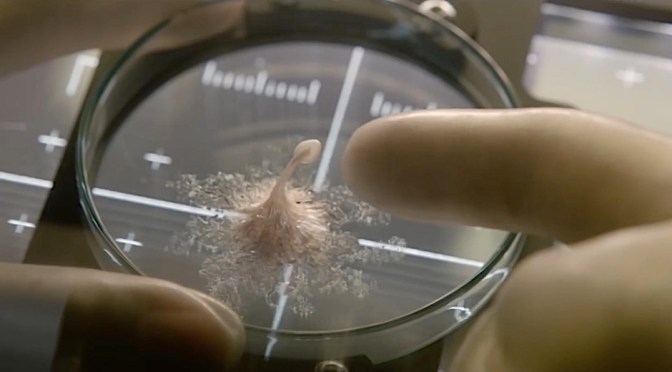
Vida

Um ótimo trabalho do brasileiro Fernando Coimbra para a Netflix
Continuar lendo Castelo de Areia →

Continuação evolui para algo maior, melhor – e até comovente. Mesmo.
Continuar lendo Guardiões da Galáxia Vol. 2 →

Inédita no cinema, esta história real é tão gostosa e reconfortante quanto canja de galinha
Continuar lendo Um Gato de Rua Chamado Bob →
Muita gente tenta, ninguém consegue: Alien continua a ser o auge da evolução
Continuar lendo Vida →

A comédia da angústia: se você já sentiu pânico no trabalho, esta série genial é para você
Continuar lendo Silicon Valley →

A série que enlouqueceu (no bom sentido), acelera sem parar e serve é para divertir mesmo – e muito
Continuar lendo Velozes e Furiosos 8 →

O trailer confirma: se você ainda não viu nada do diretor Taika Waititi, corra para ver – seu humor vai melhorar na hora
Continuar lendo O Teaser de Thor: Ragnarok →


Na Netflix, um sensacional terror passado em Teerã
Continuar lendo Sob a Sombra →

Annette Bening, radiante, em um dos grandes desempenhos do ano
Continuar lendo Mulheres do Século 20 →
Blog de Cinema e TV da jornalista Isabela Boscov.